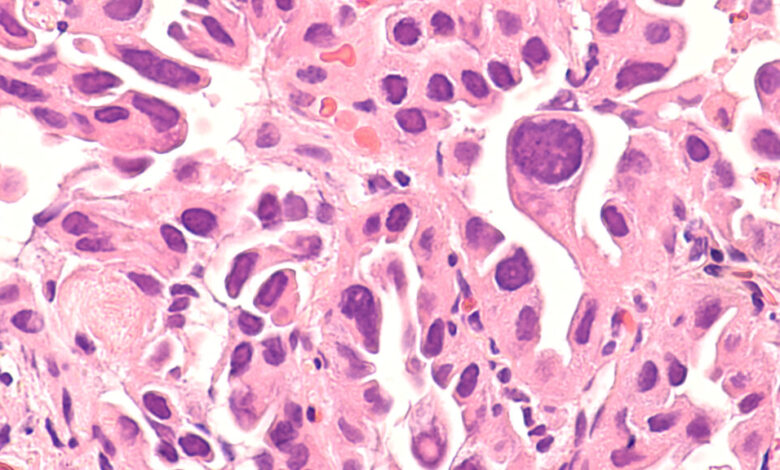

Lung cancer rise among nonsmokers prompts questions on screening
The idea is to identify high-risk individuals among non-smokers who may benefit from early screening for lung cancer. This could potentially save lives by catching the disease at an earlier, more treatable stage.
The shifting landscape of lung cancer demographics is shedding light on the importance of recognizing and addressing the unique challenges faced by never-smokers who develop the disease. From the different risk factors involved to the particular mutations found in these cases, understanding the nuances of lung cancer in non-smokers is crucial for improving outcomes and tailoring treatment strategies.
As researchers delve deeper into the reasons behind the rise in lung cancer cases among never-smokers, factors like air pollution, radon exposure, and genetic predispositions are coming into focus. By pinpointing these risk factors and developing targeted screening programs, there is hope for better detection and management of lung cancer in this population.
The conversation around lung cancer screening criteria is evolving, with calls for a more inclusive approach that considers the specific needs of never-smokers at risk. Initiatives like the study in New York and the screening program in Taiwan are paving the way for a more personalized and effective approach to lung cancer prevention and treatment.
Ultimately, the goal is to bridge the gap in lung cancer care for never-smokers and ensure that all individuals at risk have access to timely and appropriate screening and interventions. By staying vigilant and proactive in addressing the changing face of lung cancer, we can work towards reducing the burden of this deadly disease on individuals and communities worldwide. As an individual of Asian descent or someone who grew up in an area with high levels of air pollution, you may be at a higher risk for certain health conditions. This could be due to genetic factors or environmental exposures that have impacted your health over time. Additionally, if you have a job that puts you at risk, such as working long hours in a kitchen, it’s important to consider screening options, especially if you are over the age of 60.
While there are some trials and research being conducted in this area, it is clear that more funding and resources are needed to better understand how we can identify at-risk individuals and screen them earlier for potential health issues. By doing so, we can improve patient outcomes and potentially prevent the development of serious health conditions.
Incorporating early screening measures for individuals in high-risk groups could be a game-changer in the field of healthcare. By identifying potential health issues sooner, healthcare providers can intervene earlier and provide necessary treatment to prevent the progression of illnesses. This proactive approach could lead to better health outcomes and overall well-being for those at risk.
In conclusion, it is crucial to continue investing in research and resources to further understand how we can identify and screen individuals at risk for health conditions. By doing so, we can make significant strides in improving patient outcomes and overall healthcare practices. Let’s work together to prioritize early screening measures and support the health and well-being of individuals in high-risk groups.





